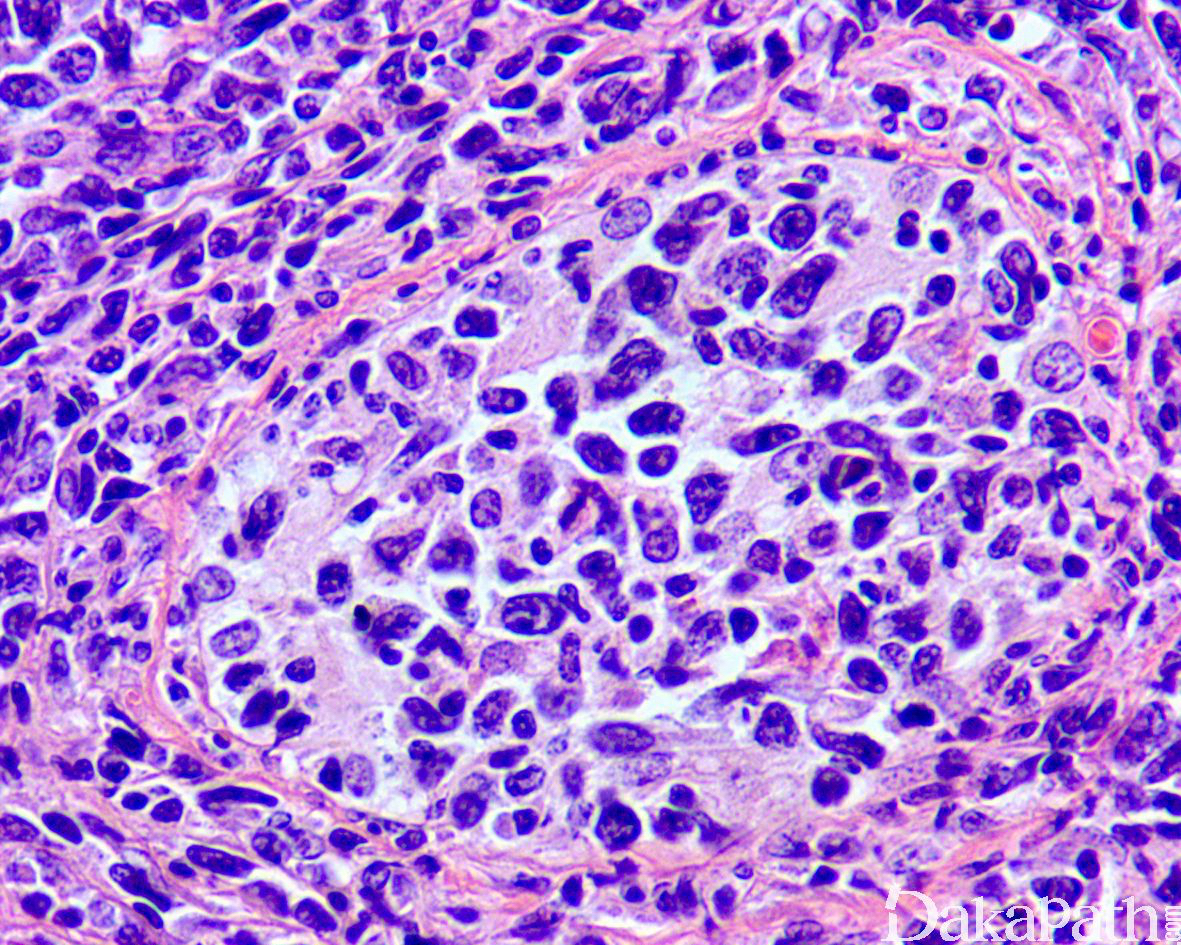
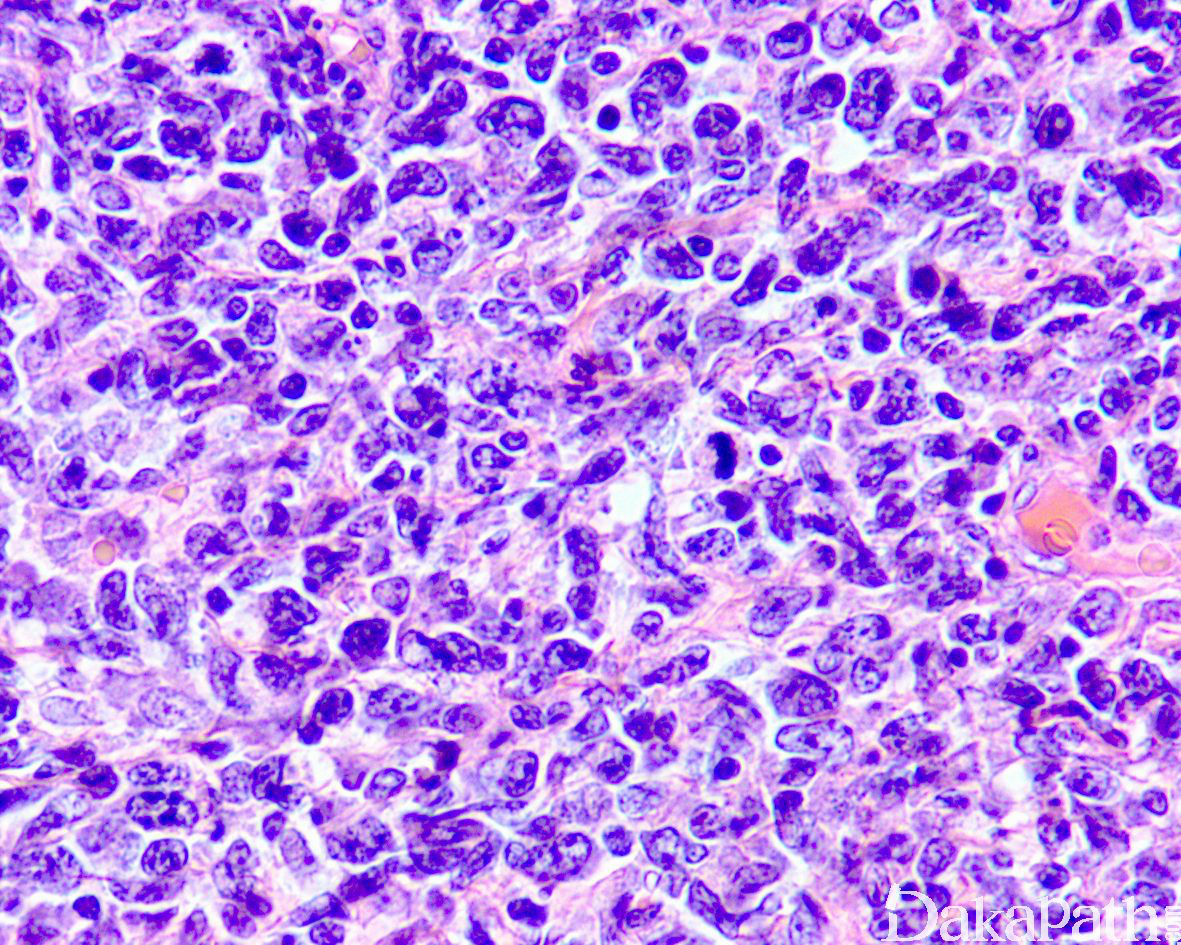

睾丸弥漫大 B 细胞淋巴瘤
Testicular Diffuse Large B-cell Lymphoma
发病部位: 睾丸
诊断要点:
主要见于老年人,60 岁以上睾丸最常见的恶性肿瘤,高峰年龄为 61-70 岁;
常表现为质硬无痛性包块,10-15%可双侧发生,最大可达 16cm;
镜下肿瘤中央区域曲细精管消失,周边区表现为曲细精管间浸润,并浸润曲细精管;
肿瘤由大的淋巴细胞构成,圆形或卵圆形,核形不规则,偶尔可见分叶核,核仁清楚,胞质稀少;
少数病例可伴硬化。
周围生精小管内无小管内原位生殖细胞肿瘤。

免疫组织化学染色:
同其它部位弥漫性大 B 细胞淋巴瘤,根据免疫表型可分为生发中心来源及非生发中性来源,一些病例可表现为双打击淋巴瘤(myc 重排伴 BCL2 和/或 BCL6 重排)。部分肿瘤细胞可表达 OCT3/4,但不表达 SALL4,因此在同睾丸生殖细胞肿瘤鉴别诊断时应予以注意。
鉴别诊断:
生殖细胞肿瘤:主要是精原细胞瘤,周围生精小管内可见原位生殖细胞肿瘤。免疫组化染色表达 OCT3/4,PLAP,SALL4 等,不表达 CD20 和 PAX5 可资鉴别。
其它类型的淋巴瘤(T 细胞或 NK/T 细胞淋巴瘤)或白血病:免疫组化染色可资鉴别。
预后:
原发的睾丸弥漫大 B 细胞淋巴瘤较继发性的预后好,5 年生存率约 60%
治疗:
睾丸切除+化疗
病例报道:
[Acaseof primarytesticulardiffuse large B-cell lymphomawith a p53 gene point mutation].
参考文献:
Diffuse Large B-cell Lymphoma** of the Testis .
Sandell RF, Erickson LA.
Mayo Clin Proc. 2016 Sep;91(9):e131-2. doi: 10.1016/j.mayocp.2016.06.016. No abstract available.
Williams A S , Shawwa A , Merrimen J , et al. Expression of OCT4 and SALL4 in Diffuse Large B-cell Lymphoma: An Analysis of 145 Consecutive Cases and Testicular Lymphomas[J]. Am J Surg Pathol 2016;40:950–957
